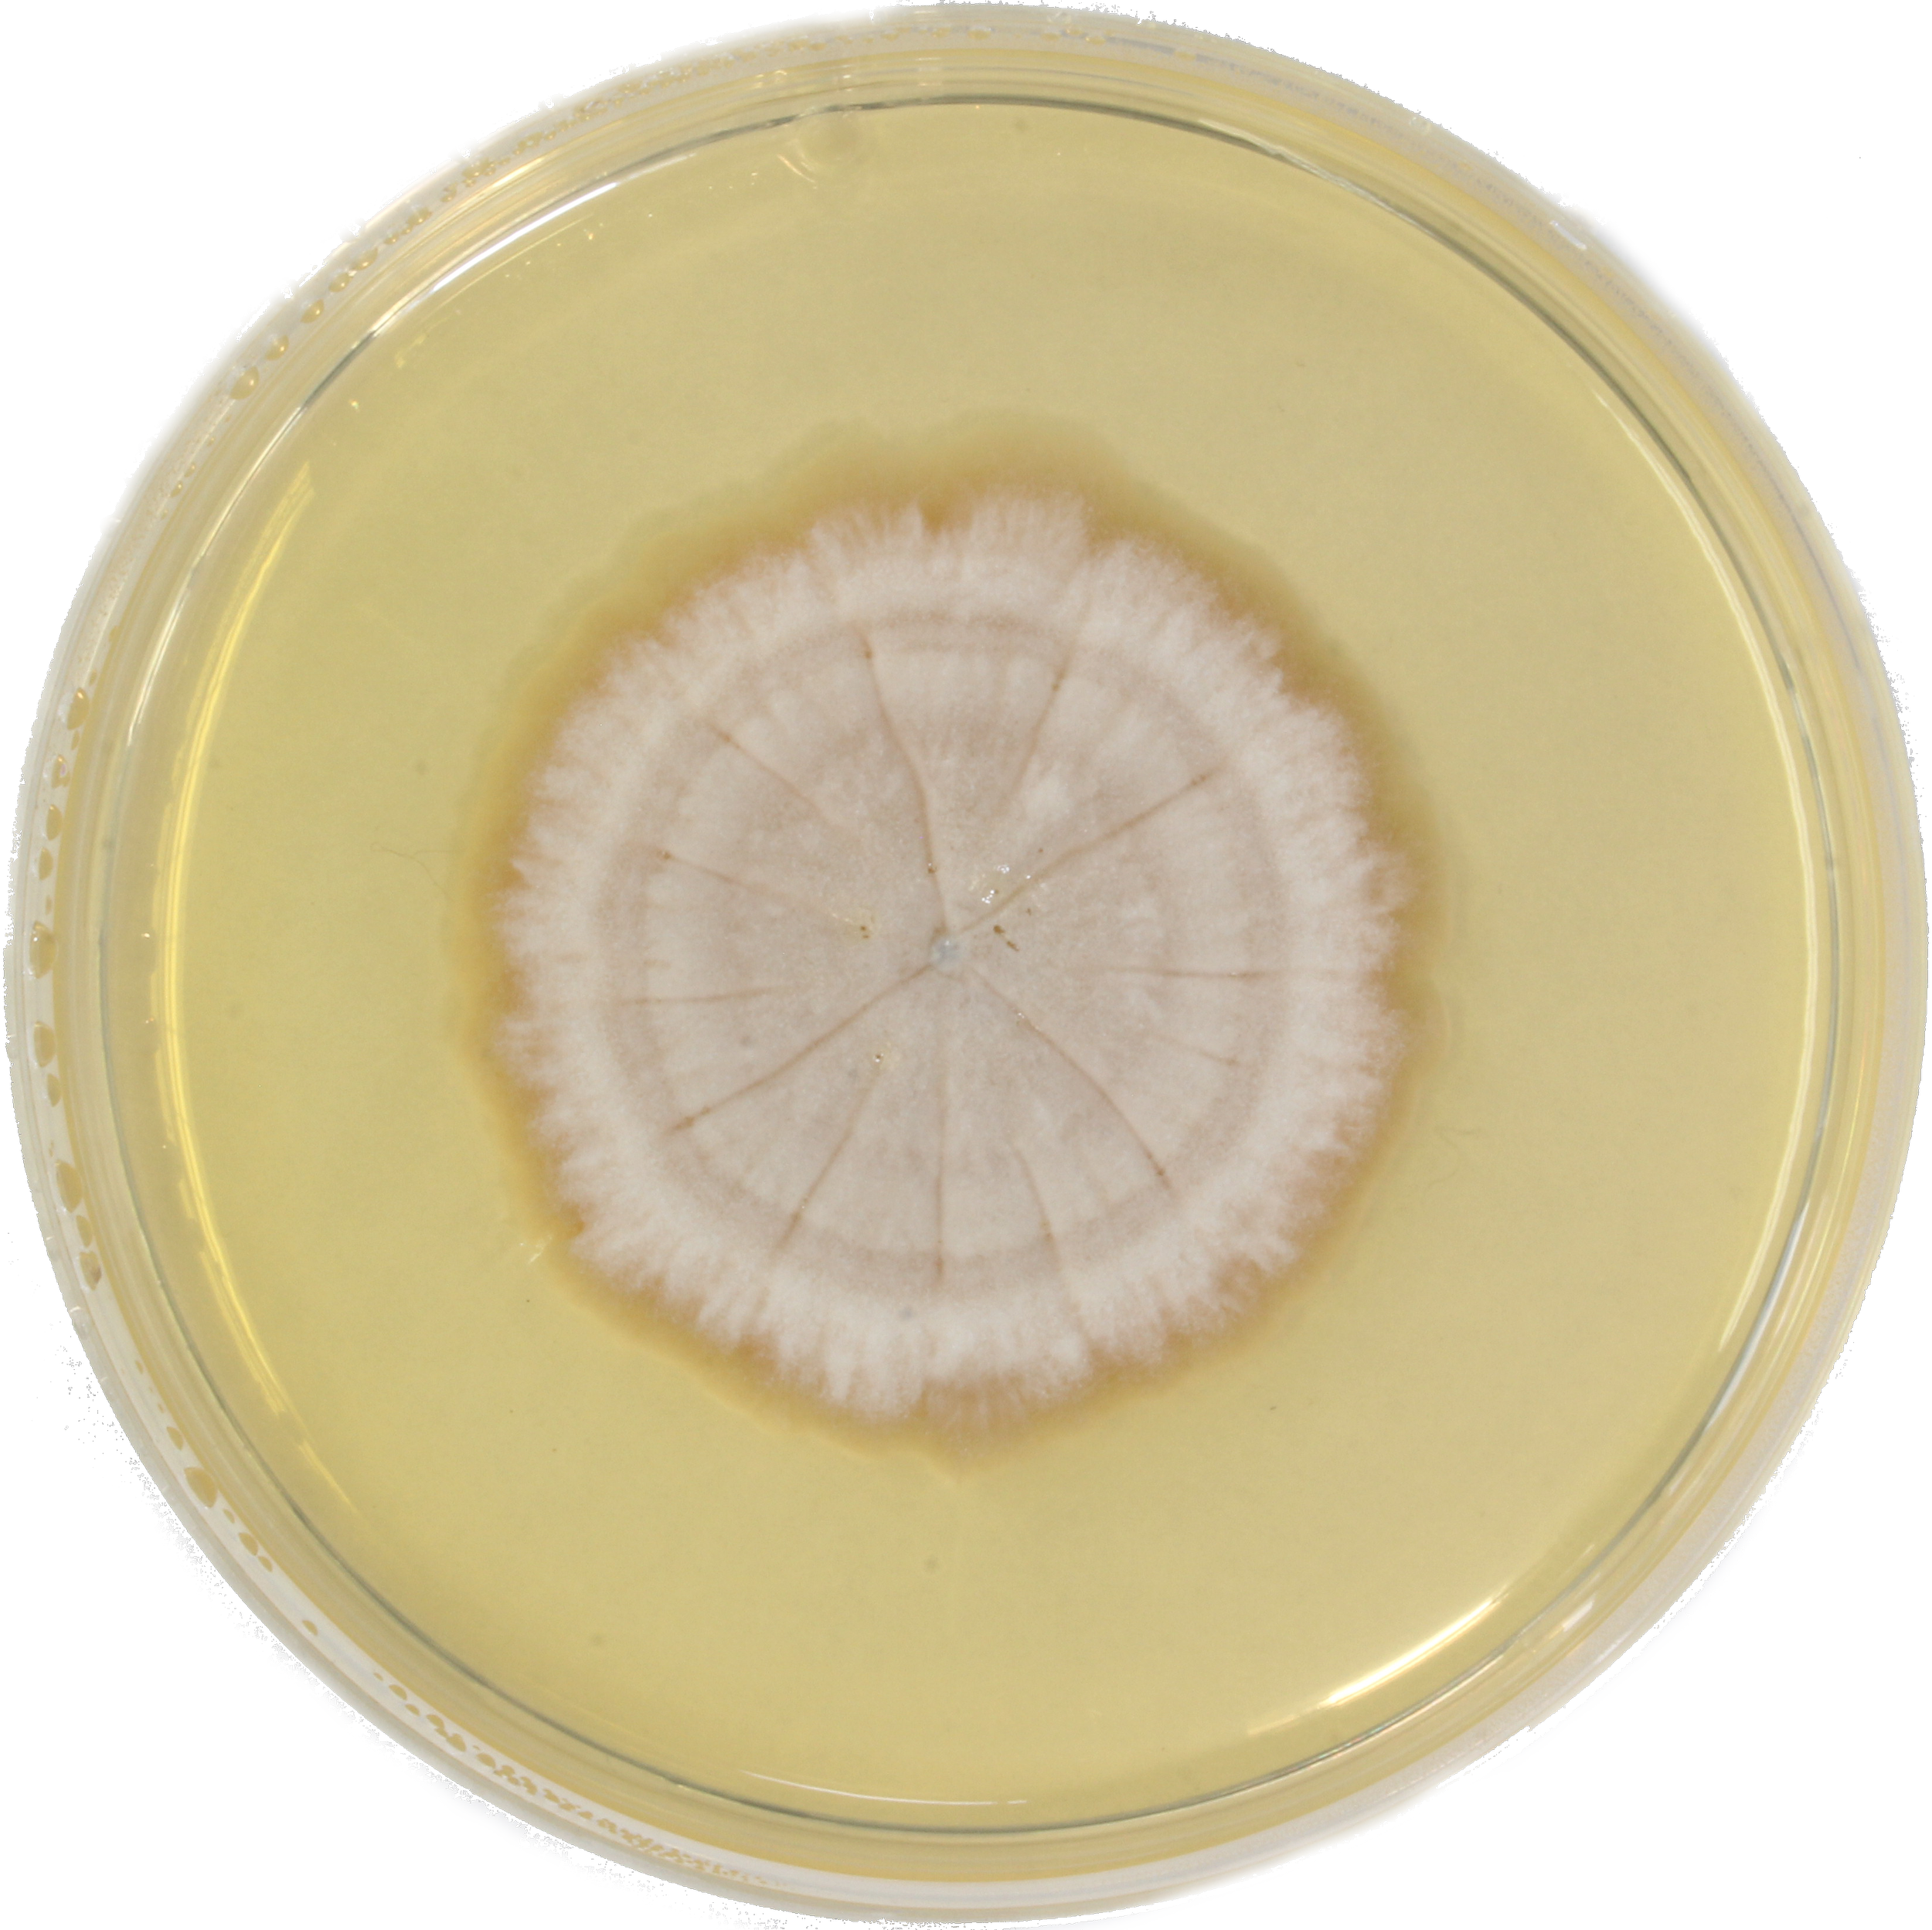

Kunst + Wissenschaft
Schimmel und Rost, eine Modekollektion, inspiriert von Zersetzungsprozessen.
In dieser Kollektion habe ich mich mit dem Thema Nachhaltigkeit auf verschiedenen Ebenen beschaeftigt. Wie kann diese in Material, Verarbeitung und visuelle Kommunikation uebersetzt werden?
Meine verwendeten Materialien waren mulesingfreie Schurwolle des Merinoschafs und geprintete Seide. Fuer die Verarbeitung der Materialien waehlte ich das Nunofilzen (Schurwolle und Seide verbinden sich zu einer textilen Flaeche) sowie das Tackern mit dem Handtacker. Ein einziges Herrenhemd wurde genaeht. Diese Abeit verorte ich als Slow Fashion Projekt. Ich habe mich dabei mit der Kunsthandwerksform des Filzens beschaeftigt und diese mit einer neuen Technologie, dem Digitaldruck, kombiniert. Das Werk veranschaulicht, die Arbeit in einem wissenschaftlichen Institut als Inspirationsquelle fuer Gestaltung.
Fuer die Praesentation der Mode waehlte ich aeltere Menschen aus. Authentik steht im Zentrum meiner kuenstlerischen Arbeit.
Mold and rust, a fashion collection inspired by decomposition processes. In this collection I have explored the theme of sustainability on various levels. How can this be translated into material, processing and visual communication? The materials I used were mulesing-free new wool from Merino sheep and printed silk. For the processing of the materials I chose nunofelting (new wool and silk combine to form a textile surface) and stapling with a hand stapler. A single men's shirt was sewn. I classify this work as a slow fashion project. I have explored the craft of felting and combined it with a new technology, digital printing. The work illustrates the work in a scientific institute as a source of inspiration for design.
For the presentation of the fashion I chose older people. Authenticity is at the center of my artistic work.